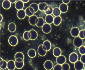

Therapeutensuche
Wählen Sie die Kategorie:
Wählen Sie das Verfahren:
Wählen Sie das Land:
Im Umkreis von:
von:
Stichwort (optional):
Zertifizierte Osteopathen
Soziales Honorar
Fremdsprache
Online-Fernberatung
Praxis für naturheilkundliche Diagnostik und Schmerztherapie, Lippstadt

Martina Döinghaus
Mastholter Str. 99
59558 Lippstadt
| Telefon: | 05248-8236333 |
| E-Mail: | E-Mail senden |
| Web: | www.heilpraktiker-lippstadt.com |
Leistungsspektrum:
Traditionelle und komplementäre Medizin, Heilkunde
Anamnese
Dunkelfelddiagnose
Heilhypnose
Lifting
Narbenentstörung
Neuraltherapie
Reiki
Sanumtherapie
Schmerztherapie
Sonstige, ergänzenden Methoden:
Krampfaderentfernung ohne Operation
Verantwortlich für den Inhalt des Eintrages ist:
Martina Döinghaus